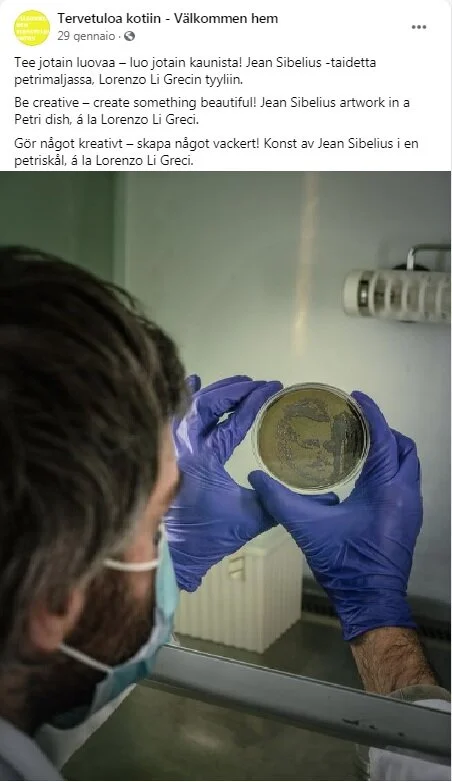

Science ∩ Art
Lorenzo Li Greci was born in 1984 in Palermo where he earned his Master Science degree at the faculty of biotechnology for industry and scientific research after a temporary residence in Basel as Erasmus student. Thereafter, he continued his academic career, carrying out research for the Telethon foundation focused on the study of the genetics of neurodegenerative diseases and publishing in the International Journal of Molecular Sciences and in the Journal of Genetics and Genomics. In 2015 he moved to Finland. Working as a researcher at the Turku Center for Biotechnology (Turku BioScience), and continuing his academic studies in Molecular Life Science, he published in Nature Communication together with the Neuronal Signaling Pathway Lab. Lorenzo started an artistic path focused on colours and materials synthesized in the laboratory. As a member of the Pargas Konstklubb PICTURA, he decides to also explore artistic languages through a scientific grammar, publishing illustrations in the Italian quarterly magazine of general culture Digressioni. He worked as a researcher in the genetics unit at MetGen, a biorefinery company in the city of Kaarina specialized in green and circular economy. He currently collaborates with MetGen Oy to produce Lignin Cascades: a permanent exhibition in industry to promote the circular economy. From 2021 Lorenzo has joined the Protein and Antibodies Engineer Unit at Orion Corporation, a pharma industry in Turku, Finland.
LINK
- PubMed
- MetGen
PRESS